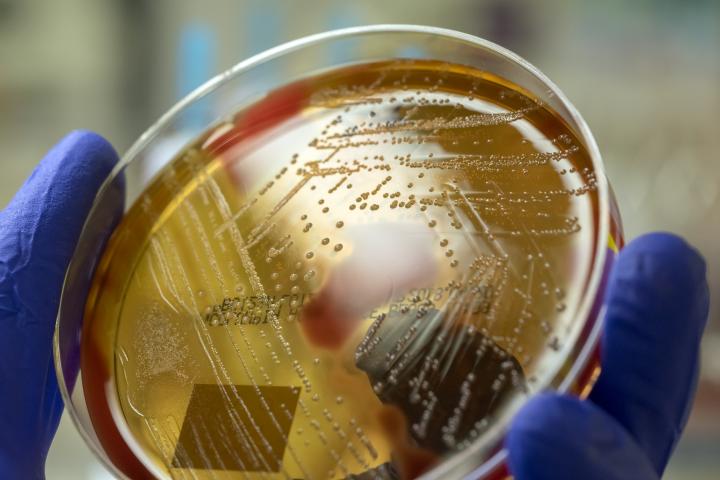
Imagen de archivo de un cultivo de Streptococcus pyogenes.

Los síntomas que produce el estreptococo A, la bacteria que preocupa por su expansión en Japón
Y cuáles son las vías de contagio.
Las autoridades sanitarias japonesas han alertado en las últimas horas sobre la propagación de una cepa de estreptococo. Concretamente, de estreptococos del grupo A (Streptococcus pyogenes), que pueden causar cuadros leves, pero en algún caso pueden desencadenar síndrome de shock tóxico estreptocócico, que tiene una mortalidad del 30%.
Por el momento, no han hallado el origen del aumento de los casos en el país nipón, donde solo entre enero y febrero se han notificado 378 —en todo 2023 hubo 941— y, al propagarse principalmente por las gotas de saliva, se está pidiendo extremar las pautas de higiene al igual que se hizo con el covid.
Los estreptococos del grupo A pueden causar infecciones de garganta y ser responsables de enfermedades como la escarlatina o el impétigo, según los CDC (Centros para el control y la prevención de enfermedades) de Estados Unidos.
Como ha informado la Cadena SER, este estreptococo puede provocar síntomas como dolor de garganta, sobre todo en niños, mientras que los adultos pueden experimentar síntomas similares a los de un resfriado común.
En algunos casos puede también incluir "faringitis estreptocócica, amigdalitis, neumonía y meningitis".
Síntomas del shock tóxico estreptocócico
Cuando se extiende a los tejidos profundos y la sangre pueden causar el ya mencionado síndrome de shock tóxico estreptocócico. "En casi la mitad de los casos, los expertos no saben cómo entró la bacteria al cuerpo de las personas. A veces, entra a través de cortes en la piel, como una lesión o una herida quirúrgica. También puede entrar al cuerpo a través de las membranas mucosas, como la piel que está adentro de la nariz y la garganta", explican los CDC, que aclaran que raramente es contagioso.
El síndrome de shock tóxico estreptocócico, que requiere tratamiento hospitalario, suele comenzar con fiebre y escalofríos, dolores musculares, náuseas y vómitos. En 24-48 horas suele bajar la presión arterial (hipotensión) y puede presentarse taquicardia, respiración acelerada e incluso insuficiencia orgánica.
Para prevenirlo, los CDC dan tres pautas: limpiar y cuidar las heridas, lavarse las manos a menudo y tomar antibióticos, en el caso de que sean recetados.
